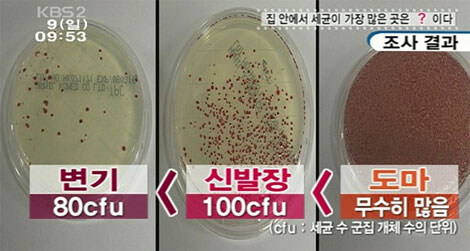

ÃßõµÇ¾ú½À´Ï´Ù.
|
| ´ÜÃà URL: https://humoruniv.com/pds1306194 URL º¹»ç |
|
|
| ¡ã ´ÙÀ½±Û | µþÀ̶û °æÀïÇÏ´Â ¾ö¸¶.manhwa | ºÒÄè¸Ç |
|
2024-05-11 [20:05] |
| ¡å ÀÌÀü±Û | °ü°èÇÒ¶§¸¶´Ù 1³â¾¿ Àþ¾îÁö´Â ³²ÀÚ.jpg | ±Í¿©¿î±ÇÁø¾Æ |
|
2024-05-11 [19:32] |
´ä±Û º£½ºÆ®
|
´ä±Û º£½ºÆ®1 |
¿¡½º´õ³É |
¿ª½Ã ½ÄŹÀ¸·Î ¾²´ø ¼±Á¶ÇйøµéÀÇ ÁöÇý°¡ ¿³º¸À̴±º [1]
|
27 0 |
|
2024-05-11 10:10 |
||||
ƼŬ |
ºÒȸ¦ »çÀü¿¡ ¸·±â À§ÇØ °â»ó ¾È ÇÏ´Â °Í¿¡µµ ÁöÇý°¡ µ¸º¸ÀÌ³× |
150 |
|
2024-05-11 |
|||||
|
´ä±Û º£½ºÆ® ¿ôÀÚ |
Âó½¸Ç |
¿ì¹°À» ¹ä»óÀ¸·Î ¾²¶ó´Â°Ô ¸»ÀÌ µÇ´Â ¼Ò¸®ÀÓ. [2]
|
10 0 |
|
2024-05-11 20:11 |
||||

|
|
À̰ʹ¾ßǰ¹ø¸ð¾ß |
www Á¡½É½Ã°£¿¡ º¯±â¿¡¼ µµ½Ã¶ô ¸Ô´Â wwwww
|
10 |
|
2024-05-11 |
||||||
|
|
¼ÒÆäÀ̽º |
ÀÌ·¡¼ ÈÀå»ì¿¡¼ ¹ä ¸Ô´Â °Å¿´±¸³ª ÁÖ¹æ°â ½ÄŹÀÌ¿´³×
|
10 |
|
2024-05-11 |
||||||
|
|
¹ÚâÀÌ |
µµ¸¶¿¡¼ ±×·¸°Ô ÀÚ¸£°í »ì¾ÆÀִ°ź¸¸é Àΰ£ ¸é¿ª ü°è°¡ °³Â¾´Ù´Â ±×¸»ÀÌ Ã¼ÇèÀÌ µÊ
|
70 |
|
2024-05-11 |
||||||
|
|
³Û»õ²¿ |
¿ª½Ã û°áÀÇ ´ë¸í»ç º¯±âÁÂ
|
20 |
|
2024-05-11 |
||||||
|
|
Å©·¹À̱×ÅÍÄ¿ |
¾î¾Áö Àú¹ø¿¡ ¹äºñ¸ç¸Ô´Âµ¥ ¹èÅ»µµ ¾È°É¸®´õ¶ó
|
10 |
|
2024-05-11 |
||||||
|
|
¿ä°³ |
±×·³ µµÀÚ±â·Î µµ¸¶¸¦ ¸¸µå´Â°Ô ÁÁÁö ¾Ê³ª?
|
00 |
|
2024-05-11 |
||||||
|
|||||||||||
À̼øÀç´©µåȺ¸ |
±×·¯´Ï±î Ä®´ë½Å ¾ûµ¢ÀÌ·Î ½ä¸é µÇÁö
|
00 |
|
2024-05-12 |
|||||||
|
|
¿¡½º´õ³É |
¿ª½Ã ½ÄŹÀ¸·Î ¾²´ø ¼±Á¶ÇйøµéÀÇ ÁöÇý°¡ ¿³º¸À̴±º
|
270 |
|
2024-05-11 |
||||||
ƼŬ |
ºÒȸ¦ »çÀü¿¡ ¸·±â À§ÇØ °â»ó ¾È ÇÏ´Â °Í¿¡µµ ÁöÇý°¡ µ¸º¸À̳×
|
150 |
|
2024-05-11 |
|||||||
|
|
Æ®·çÆú½º |
±×·¡¼ ÈÀå½Ç°ú ÁÖ¹æÀÌ ÇÕÃÄÁø ÁýµéÀÌ ³ª¿À´Â°ÅÀݾî
|
20 |
|
2024-05-11 |
||||||
|
|
¼ÒÁÖ¿Õv |
º»¹®°ú »ó°ü¾ø±ä Çѵ¥ ³ª¹« ½Ä±â´Â Àß »î¾Æµµ ¾È µÇ³ª? ¿¹Àü¿¡ »çµÐ ´©´õ±â Àá¿Ê ÀÔÀ¸·Á°í ³ª¹« ½Ä±â »ç³ù´Âµ¥
|
10 |
|
2024-05-11 |
||||||
|
|||||||||||
|
|
LostArk |
°«±â
|
00 |
|
2024-05-11 |
||||||
|
|
³ÍÇ×»ó±×·±½ÄÀÌ¾ß |
¾Æ ±×·¡¼ Á¢¶§ ÈÀå½Ç¿¡¼ ¹ä¸Ô´Â´Ù´Â ±ÛÀÌ ÀÖ¾ú±¸³ª
|
00 |
|
2024-05-11 |
||||||
|
|
ÇູÀüµµ»çÀÔ´Ï´Ù |
¤©¤· º¯±â ±ú²ýÇÏÁö!
|
00 |
|
2024-05-11 |
||||||
|
|||||||||||
|
|
ÆÒ¾Æ¸Þ¸®ÄÇ×°ø |
½ºÆ¿
|
20 |
|
2024-05-11 |
||||||
|
|
±â¸®±â±â |
¶ô½º¼Òµ¶ Çϼ¼¿ä
|
00 |
|
2024-05-11 |
||||||
|
|
¶óµåÀ¯ |
º¯±â´Â ¿ìÁÖ¿¡¼ °¡Àå û°áÇÑ ¹°Ã¼ÀÓ
|
40 |
|
2024-05-11 |
||||||
|
|
¼Ö¹Ø |
¤»¤»¤» ¸é¿ª·Â °È È¿°ú ¤»¤»¤»
|
00 |
|
2024-05-11 |
||||||
|
|
Âó½¸Ç |
¿ì¹°À» ¹ä»óÀ¸·Î ¾²¶ó´Â°Ô ¸»ÀÌ µÇ´Â ¼Ò¸®ÀÓ.
|
100 |
|
2024-05-11 |
||||||
Âó½¸Ç |
?
|
40 |
|
2024-05-11 |
|||||||
¾î½ºÀ©µå¾ØµåÆÄÀ̾î |
ÈÀå½Ç¼Ó ¿Ë´Þ»ù ´©°¡¿Í¼ ¸Ô´Ï¿ä~
|
00 |
|
2024-05-12 |
|||||||
|
|
°í¼ÒÇÑ¿ìÀ¯ |
¿ª½Ã ¹ä¸Ô´Â°÷Àº û°áÇÏÁö
|
10 |
|
2024-05-11 |
||||||
|
|
·¹³ë¹Ì |
º¯±â ÀçÁúÀÌ µµÀڱ⿴¾î? ³ ±×µ¿¾È ÇÃ¶ó½ºÆ½À¸·Î ¾Ë°í ÀÖ¾ú´Âµð.. ±× Áß¿¡¼µµ ¾ÆÅ©¸± °°Àº°É·ç¸»¾ß. ÀÌ ±âȸ¿¡ ÇÑ ¹ø °Ë»öÇØºÁ¾ß°Ú´Ù
|
00 |
|
2024-05-11 |
||||||
|
|||||||||||
¾î½ºÀ©µå¾ØµåÆÄÀ̾î |
Á¤È®È÷´Â ¼¼¶ó¹Í! ¾îÂ÷ÇÇ ´Ù À¯¾à ¹ß¶ó¼ ±Á´Â °Å´Ï±ñ ¤»¤µ¤»
|
10 |
|
2024-05-12 |
|||||||
|
|
ºñÁ¤»óȸ´ã |
º¯±â À§¿¡¼ µµ¸¶´ë½Å ½ä±â ¿îµ¿
|
00 |
|
2024-05-11 |
||||||
|
|
ÁöÇÏÇÙº¡Ä¿ |
µµ¸¶¿£ ¶ËÀ» ½Î¸é µÇ´Â°Ç°¡
|
00 |
|
2024-05-11 |
||||||
|
|
´ëÇÐÀ»°¡¾ßÇϳª¸»¾Æ¾ß |
½Î°íưưÇÑ Èò»ö ¾÷¼Ò¿ëµµ¸¶ ¿©·¯°³»ç³õ°í¾²´ÂÁß ¼Òµ¶µµ ÀÚÁÖÇÏ¸é ´õ ÁÁÀº°Å°°À½
|
00 |
|
2024-05-12 |
||||||
|
|
°õ¼®¼ès |
ÈÀå½Ç¿¡¼ ¹ä ¸Ô´Â »ç¶÷µéÀº º¯±â À§¿¡ ¹ÝÂù ¿Ã·Á¼ ¸Ô´Â±¸³ª..
|
00 |
|
2024-05-12 |
||||||
|
|
¹éÆ÷½º |
±×·¯´Ï±ñ À°º¯±â¶õ ¸»Àº ¸öÀÌ ±ú²ýÇϴٴ°ÅÁö?
|
10 |
|
2024-05-12 |
||||||
|
|
¹ÝÃßµ¿¹°¿µ¾çÇÐ |
8¡¿10^1 cfu¶û 1¡¿10^2 cfu Àε¥ ÄÝ·Î´Ï Â÷ÀÌ ¿ÖÀú·¡ »çÁø »ç±âÄ¡³×
|
00 |
|
2024-05-12 |
||||||
|
|
¾ÆÅ©ºñ¼ó |
»ì¸² Àß ¾ÈÇØ¼ ³ª´Â ¶â¾î¾²´Â µµ¸¶ ¾¸.... Çѵιø ¾²°í ¹ö¸² µµ¸¶°ü¸® ¸øÇϰھû
|
00 |
|
2024-05-12 |
||||||
|
|
¹äÇѳ¢ÁÖ¼Ò |
°ü¸®¸¦ Á¦´ë·Î ¸øÇؼ »ý±â´Â ¹®Á¦ ¾Æ´Ò±î ½Í±â´Â Çѵ¥....
|
00 |
|
2024-05-12 |
||||||
|
|
·Î·Î·Î·Î·Î·Î |
¸í.ǰ.½Ä.Ź
|
00 |
|
2024-05-12 |
||||||
|
|
µµ¾ßÄô |
ÇÃ¶ó½ºÆ½µµ Çâ±ÕÁ¦ ¼¯¾î¼ »çÃâÇѰŠÀÖÀ½, ±×°Å ½á~!
|
00 |
|
2024-05-20 |
||||||
»ó´ë¹æ¿¡ ´ëÇÑ ¹è·Á´Â ³×ƼÄÏÀÇ ±âº»ÀÔ´Ï´Ù.°Ô½Ã¹°¿¡ »ó°ü¾ø´Â ´ä±ÛÀ̳ª ÃßõÀ¯µµ¼º ´ä±ÛÀ» ´ÞÁö ¸¶¼¼¿ä.
½ºÆ÷ÀÏ·¯¼º ´ä±ÛÀÌ ½Å°íµÇ°Å³ª ¹ß°ßµÇ¸é ÀÌÀ¯ºÒ¹® »èÁ¦ ȤÀº Á¤ÇÐó¸® µË´Ï´Ù. À¯ÀÇ ºÎŹ µå¸³´Ï´Ù.
| ¡ã ´ÙÀ½±Û | µþÀ̶û °æÀïÇÏ´Â ¾ö¸¶.manhwa | ºÒÄè¸Ç |
|
2024-05-11 [20:05] |
| ¡å ÀÌÀü±Û | °ü°èÇÒ¶§¸¶´Ù 1³â¾¿ Àþ¾îÁö´Â ³²ÀÚ.jpg | ±Í¿©¿î±ÇÁø¾Æ |
|
2024-05-11 [19:32] |
